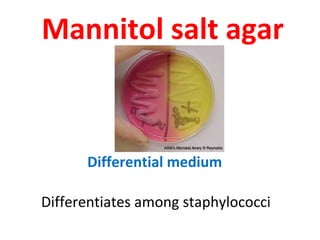
Mannitol salt agar



      Differential medium

Differentiates among staphylococci
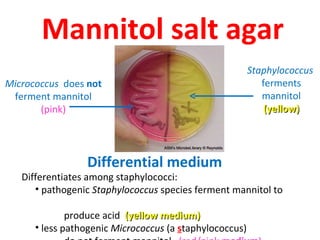
Mannitol salt agar
                                                         Staphylococcus
Micrococcus does not                                        ferments
 ferment mannitol                                           mannitol
       (pink)                                                (yellow)




                 Differential medium
   Differentiates among staphylococci:
      • pathogenic Staphylococcus species ferment mannitol to

              produce acid (yellow medium)
      • less pathogenic Micrococcus (a staphylococcus)
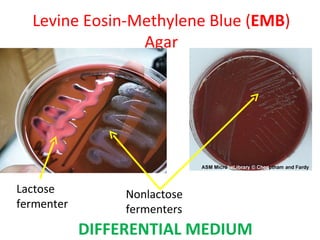
Levine Eosin-Methylene Blue (EMB)
                Agar




Lactose          Nonlactose
fermenter        fermenters
            DIFFERENTIAL MEDIUM
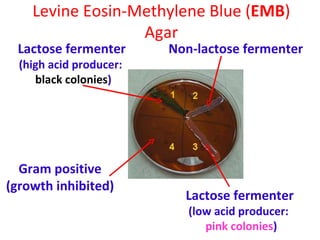
Levine Eosin-Methylene Blue (EMB)
                  Agar
 Lactose fermenter       Non-lactose fermenter
  (high acid producer:
     black colonies)




  Gram positive
(growth inhibited)
                           Lactose fermenter
                            (low acid producer:
                               pink colonies)
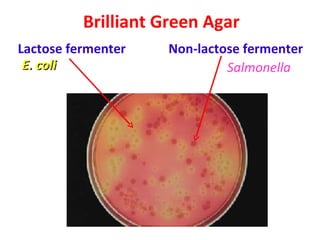
Brilliant Green Agar
Lactose fermenter   Non-lactose fermenter
 E. coli                     Salmonella
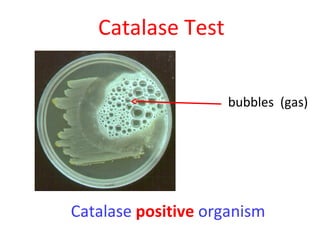
Catalase Test


                     bubbles (gas)




Catalase positive organism

This document discusses various biochemical tests and diagnostic media used to identify bacteria. It describes selective and differential media, including Mannitol salt agar, Eosin methylene blue (EMB) agar, and Brilliant green agar. It explains how these media selectively inhibit or allow growth of certain bacteria and can differentiate bacteria based on properties like lactose fermentation or catalase production.